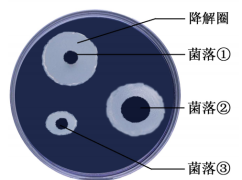

- 培养基对微生物的选择利用
- 共60题
下列有关NaCl在生物技术实践中的应用,正确的是( )
正确答案
解析
略
知识点
31.(8 分)人工瘤胃模仿了牛羊等反刍动物的胃,可用来发酵处理秸秆,提高秸秆的营养价值。
为了增强发酵效果,研究人员从牛胃中筛选纤维素酶高产菌株,并对其降解纤维素能力进行了研究。 请回答下列问题:
(1)在样品稀释和涂布平板步骤中,下列选项不需要的是____(填序号)。
①酒精灯 ②培养皿 ③显微镜 ④无菌水
(2)在涂布平板时,滴加到培养基表面的菌悬液量不宜过多的原因是____。
(3)向试管内分装含琼脂的培养基时,若试管口粘附有培养基,需要用酒精棉球擦净的原因是 ____。
(4)刚果红可以与纤维素形成红色复合物,但并不与纤维素降解产物纤维二糖和葡萄糖发生这种反应。 研究人员在刚果红培养基平板上,筛到了几株有透明降解圈的菌落(见上图)。 图中降解圈大小与纤维素酶的____有关。 图中降解纤维素能力最强的菌株是____(填图中序号)。
(5)研究人员用筛选到的纤维素酶高产菌株 J1 和 J4,在不同温度和 pH 条件下进行发测得发酵液中酶活性的结果见下图,推测菌株 更适合用于人工瘤胃发酵,理是____。
正确答案
(1)③
(2)培养基表面的菌悬液会出现积液,导致菌体堆积,影响分离效果
(3)避免培养基污染棉塞
(4)量与活性 ①
(5)J4 发酵过程会产热和产酸,J4 菌株在较高温度和酸性环境下酶的活性更高
解析
解析已在路上飞奔,马上就到!
知识点
临床试用抗生素前,有时需要做细菌耐药实验。实验时,首先要从病人身上获取少量样本,然后按照一定的实验步骤操作,以确定某致病菌对不同抗生素的敏感性。
回答下列问题:
(1)为了从样本中获取致病菌菌落,可用_______法或_________法将样本借种于固体培养基表面,经过选择培养、鉴别等步骤获得。
(2)取该单菌落适当稀释,用______法接种于固体培养基表面,在37℃培养箱中培养24h,使其均匀生长,布满平板。
(3)为了检测该致病菌对于抗生素的敏感性,将分别含有A,B,C,D四种抗生素的滤纸片均匀置于该平板上的不同位置,培养一段时间后,含A的滤纸片周围出现透明圈,说明该致病菌对抗生素A_______;含B的滤纸片周围没有出现透明圈,说明该致病菌对抗生素B_____;含C的滤纸片周围的透明圈比含A的小,说明________;含D的滤纸片周围的透明圈也比含A的小,且透明圈中出现了一个菌落,在排除杂菌污染的情况下,此菌落很可能是抗生素D的________。
(4)根据上述实验结果,为达到抗菌目的,最好应选择抗生素_______。
正确答案
答案:(1)划线;稀释涂布(或涂布)
(2)涂布
(3)敏感;不敏感;该致病菌对C的敏感性比对A弱;耐药菌
(4)A
解析
本题考查微生物的培养和应用。
(1)分离菌落常用稀释涂布平板法或划线涂布法。
(2)取该单菌落适当稀释,用涂布法接种于固体培养基表面,适宜温度培养。(3)含抗生素的滤纸片周围出现透明圈,说明该致病菌对该抗生素有敏感性,周围没有透明圈的说明该抗生素不具有敏感性。透明圈越大的敏感性越强。
(4)实验结果抗生素A对该致病菌的作用最好。
知识点
下列关于科学研究方法与实验目的叙述正确的是
正确答案
解析
略
知识点
以下为选作部分,请从下面两题中选择一题作答,多做的则按第一题评分。
35.乳糖酶能够催化乳糖水解为葡萄糖和半乳糖,具有重要应用价值。乳糖酶的制备及固定化步骤如下:
(1)筛选产乳糖酶的微生物L时,宜用_______
(2)培养微生物L前,宜采用__________方法对接种环进行灭菌。
(3)纯化后的乳糖酶可用电泳法检测其分子量大小。在相同条件下,带电荷相
(4)乳糖酶宜采用化学结合法(共价键结合法)进行固定化,可通过检测固定化乳糖酶的___________确定其应用价值。除化学结合法外,酶的固定化方法还包括___________、_____________、离子吸附法及交联法等。
36.治疗性克隆对解决供体器官缺乏和器官移植后免疫排斥反应具有重要意义。流程如下:
(1)过程①采用的是细胞工程中的_________技术,过程②采用的是胚胎工程中的_________技术。
(2)体细胞进行体外培养时,所需气体主要有O2和CO2,其中CO2的作用是维持培养液(基)的_____________。
(3)如果克隆过程中需进行基因改造,在构建基因表达载体(重组载体)时必须使用_______和__________两种工具酶。基因表达载体上除目的基因外,还需有________基因,以便选出成功导入基因表达载体的细胞。
(4)胚胎干细胞可以来自于囊胚中的________。在一定条件下,胚胎干细胞可以分化形成不同的组织器官。若将图中获得的组织器官移植给个体_________(填“A”或“B”),则不会发生免疫排斥反应。
正确答案
35.(1)乳糖 凝固剂 选择培养基
(2)灼烧
(3)小
(4)(
解析:(1)已知乳糖乳糖酶能够催化乳糖水解为葡萄糖和半乳糖,筛选产乳糖酶的微生物L时,宜用
(2)为了避免杂菌污染,在培养微生物前,对接种环等接种工具应采用灼烧灭菌。
(3)用电泳法纯化乳糖酶时,若在相同条件下分离带电荷相同的蛋白质,则其分子量越小,电泳速度越快。
(4)固定化酶的应用价值与酶的活性(或活力)有关,因此用化学结合法固定化乳糖酶时,可通过检测固定化乳糖酶的活性(或活力)来确定其应用价值。固定酶
36.(1)(体细胞)核移植 (早期)胚胎培养
(2)PH(或酸碱度)
(3)限制性(核酸)内切酶(或限制酶) DNA连接酶(注:两空可颠倒) 标记
(4)内细胞团 B
解析:(1)过程①表示将从体细胞中分离出的细胞核与去核的卵(母)细胞重组形成重组细胞的过程,因此采用的是细胞工程中的(体细胞)核移植技术。过程②表示将重组细胞培养才早期胚胎的过程,所以采用的是胚胎工程中的(早期)胚胎培养技术。
(2)在动物细胞培养时,CO2的主要作用是维持培养液(基)的PH(或酸碱度)。
(3)在基因工程中,在构建基因表达载体(重组载体)时必须使用限制性(核酸)内切酶(或限制酶)和DNA连接酶。基因表达载体的组成,除目的基因外,还必须有启动子、终止子以及标记基因等,其中标
(4)胚胎干细胞可以来自于囊胚中的内细胞团。图中获得的组织器官,其细胞核来自于个体B,其遗传物质组成几乎与个体B相同,因此将该组织器官移植给个体B则不会发生免疫排斥反应。
解析
解析已在路上飞奔,马上就到!
知识点
扫码查看完整答案与解析